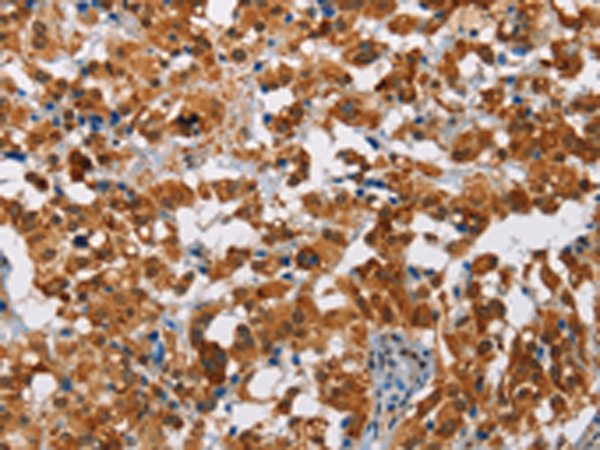

中文名稱:兔抗ATXN1多克隆抗體
|
Background: |
The autosomal dominant cerebellar ataxias (ADCA) are a heterogeneous group of neurodegenerative disorders characterized by progressive degeneration of the cerebellum, brain stem and spinal cord. Clinically, ADCA has been divided into three groups: ADCA types I-III. ADCAI is genetically heterogeneous, with five genetic loci, designated spinocerebellar ataxia (SCA) 1, 2, 3, 4 and 6, being assigned to five different chromosomes. ADCAII, which always presents with retinal degeneration (SCA7), and ADCAIII often referred to as the `pure' cerebellar syndrome (SCA5), are most likely homogeneous disorders. Several SCA genes have been cloned and shown to contain CAG repeats in their coding regions. |
|
Applications: |
ELISA, IHC |
|
Name of antibody: |
ATXN1 |
|
Immunogen: |
Fusion protein of human ATXN1 |
|
Full name: |
ataxin 1 |
|
Synonyms: |
ATX1; SCA1; D6S504E |
|
SwissProt: |
P54253 |
|
ELISA Recommended dilution: |
1000-5000 |
|
IHC positive control: |
Human thyroid cancer and human brain |
|
IHC Recommend dilution: |
50-200 |
購(gòu)物車
幫助
021-54845833/15800441009
